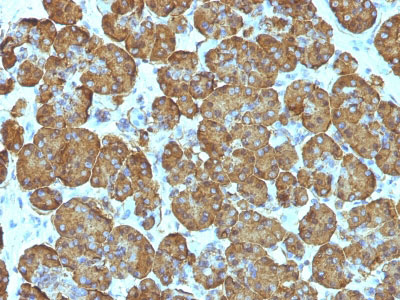

> Antigen, Antibodies, ELISA, Western Blot > Primary Antibody > Monoclonal Antibodies > Cytochrome C (Mitochondrial Marker) AntibodyBrand |
Leading Biology | Catalog Number |
APR07319G |
Product Type |
Monoclonal Antibodies | Field of Research |
|
Product Overview |
We constantly strive to ensure we provide our customers with the best antibodies. As a result of this work we offer this antibody in purified format.
We are in the process of updating our datasheets. If you have any questions regarding this update, please feel free to contact our technical support team.
This product is a high quality Cytochrome C (Mitochondrial Marker) antibody.
|
||
Molecular Weight |
15kDa
|
||
Cellular Localization |
Antigen Cellular Localization:
Mitochondrion intermembrane space. Note=Loosely associated with the inner membrane
|
||
Host |
Mouse
|
||
Species Reactivity |
Human, Mouse, Rat, Horse, Dog
|
||
Clone |
SPM389
|
||
Isotype |
Mouse / IgG2b, kappa
|
||
Symbol |
CYC
|
||
GeneID |
|||
UniProt ID |
|||
Function |
Electron carrier protein. The oxidized form of the cytochrome c heme group can accept an electron from the heme group of the cytochrome c1 subunit of cytochrome reductase. Cytochrome c then transfers this electron to the cytochrome oxidase complex, the final protein carrier in the mitochondrial electron-transport chain.
|
||
Summary |
It recognizes an epitope within amino acids 93-104 of pigeon Cytochrome C, a well-characterized mobile electron transport protein that is essential to energy conversion in all aerobic organisms. In mammalian cells, this highly conserved protein is normally localized to the mitochondrial inter-membrane space. More recent studies have identified cytosolic cytochrome c as a factor necessary for activation of apoptosis. During apoptosis, cytochrome c is trans-located from the mitochondrial membrane to the cytosol, where it is required for activation of caspase-3 (CPP32). Overexpression of Bcl-2 has been shown to prevent the translocation of cytochrome c, thereby blocking the apoptotic process. Overexpression of Bax has been shown to induce the release of cytochrome c and to induce cell death. The release of cytochrome c from the mitochondria is thought to trigger an apoptotic cascade, whereby Apaf-1 binds to Apaf-3 (caspase-9) in a cytochrome c-dependent manner, leading to caspase-9 cleavage of caspase-3. This MAb recognizes total cytochrome C which includes both apocytochrome (i.e. cytochrome in the cytosol without heme attached) and holocytochrome (i.e cytochrome in the mitochondria with heme attached).
|
||
Form |
Liquid. In PBS containing 0.02% sodium azide. |
||
Storage & Stability |
Store at +4°C short term. For long-term storage, aliquot and store at -20°C or below. Stable for 12 months at -20°C. Avoid repeated freeze-thaw cycles.
|
||
Applications |
WB, IHC, IF, FC
|
||
Synonyms |
Cytochrome c, CYCS, CYC
|
||
Images |

Formalin-fixed, paraffin-embedded human Salivary Tumor stained with Cytochrome C Monoclonal Antibody (SPM389).
Formalin-fixed, paraffin-embedded human Pancreas stained with Cytochrome C Monoclonal Antibody (SPM389). |
||
Specification |
|||
Quantity |
|
||
| Select | Brand | Catalog No. | Product Name | Pack Size | Type | Field of Research | Specification | Quantity | Price(USD) | |
| 1 | Leading Biology | APG02467G | CCK4 / PTK7 Antibody (clone 4F9) | 50 μl | Monoclonal Antibodies |
|
$495.00 | Add Ask | ||
| 2 | Leading Biology | AMM04683G | GALT Antibody (clone 4C11) | 50 μg | Monoclonal Antibodies |
|
$545.00 | Add Ask | ||
| 3 | Leading Biology | AMM01402G | Vimentin (Mesenchymal Cell Marker) Antibody - With BSA and Azide | 50 ug | Monoclonal Antibodies |
|
$395.00 | Add Ask | ||
| 4 | Leading Biology | APR08280G | LTA4H / LTA4 Antibody (clone 9G8) | 50 μl | Monoclonal Antibodies |
|
$495.00 | Add Ask | ||
| 5 | Leading Biology | AMM00172G | CD1a / HTA1 (Mature Langerhans Cells Marker) Antibody - With BSA and Azide | 50 ug | Monoclonal Antibodies |
|
$395.00 | Add Ask | ||
| 6 | Leading Biology | AMM05750G | CEBPA Antibody | 100 μl | Monoclonal Antibodies |
|
$545.00 | Add Ask |
 Leading Biology Inc.
2600 Hilltop DR, Building G, B Suite C138
Richmond, CA, 94806
Tel: 1-661-524(LBI)-0262
Email: info@leadingbiology.com
Leading Biology Inc.
2600 Hilltop DR, Building G, B Suite C138
Richmond, CA, 94806
Tel: 1-661-524(LBI)-0262
Email: info@leadingbiology.com
Complete this form and click send to ask us a question, request a quote or simply say hello.

You have 0 item in your cart

You have 0 item in your inquiry list
